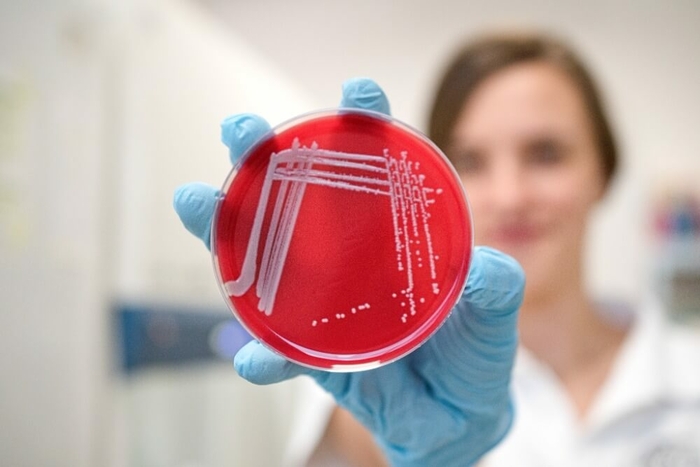

„Je naším posláním, abychom vytvořili odpovědné a udržitelné prostředí."
Martin Klimánek, rektor
Pět pilířů udržitelné MENDELU

Strategie řízení
Mendelova univerzita v Brně staví na transparentním a udržitelném řízení, které reflektuje Zelenou dohodu pro Evropu, Agendu 2030 OSN a strategické cíle ČR. Efektivní správa zdrojů, digitalizace a snižování uhlíkové stopy jsou klíčové pro náš dlouhodobý rozvoj. Strategický záměr MENDELU 2025–2030 integruje udržitelnost do všech oblastí univerzitního fungování – od provozu kampusu po vzdělávání a inovace. Jsme moderní univerzitou, která nejen reaguje na klimatické výzvy, ale aktivně se podílí na jejich řešení.

Vzdělávací činnost
Udržitelnost se stává stále důležitějším tématem a vzdělávání by mělo hrát klíčovou roli při podpoře udržitelné budoucnosti. V této době se na všechny sektory společnosti klade velký tlak, aby přijaly zodpovědné postupy a přispěly ke snižování vlivu na životní prostředí. MENDELU není výjimkou a snaží se být průkopníkem v oblasti udržitelnosti. Univerzita si klade za cíl systematicky začleňovat témata udržitelného rozvoje do všech studijních programů napříč fakultami.

Tvůrčí činnost
Mendelova univerzita v Brně podporuje inovativní výzkum a tvůrčí činnost, které přispívají k udržitelnému rozvoji a odpovědnému hospodaření s přírodními zdroji. Naše vědecké aktivity se zaměřují na environmentálně šetrné technologie, udržitelné zemědělství a cirkulární ekonomiku. Klíčovou roli hraje i transfer znalostí – propojujeme akademické poznatky s praxí a pomáháme zavádět udržitelné inovace do firem i veřejného sektoru. Prostřednictvím spolupráce s partnery na lokální i mezinárodní úrovni tak přispíváme k řešení globálních výzev.

Provoz a správa univerzity
V rámci naší strategie udržitelnosti klademe důraz na odpovědný provoz a správu areálu. Investujeme do fotovoltaiky, abychom snížili naši spotřebu energie z neobnovitelných zdrojů, a optimalizujeme hospodaření s vodou, aby se zbytečně neplýtvalo. Pečlivě třídíme odpady a hledáme cesty, jak je dále využít. Zároveň se staráme o rozvoj zeleně v areálu, která přispívá k lepšímu mikroklimatu i celkové kvalitě prostředí. Udržitelnost pro nás není jen slovo – je to každodenní součást našeho fungování.

Společenská odpovědnost a třetí role
Formování a tvoření veřejného mínění, reakce na společenské výzvy, partnerství a spolupráce, odpovědný přístup. Tváří v tvář stupňující se klimatické krizi a rostoucí sociální nerovnosti se udržitelnost a sociální odpovědnost staly zásadními problémy. Jádrem těchto konceptů je poznání, že musíme jednat hned, abychom zajistili blahobyt současných i budoucích generací. MENDELU chce aktivně přispívat k udržitelnému rozvoji regionu prostřednictvím expertní spolupráce, osvětových aktivit a sdílení znalostí s veřejností.
Prioritní cíle MENDELU
Inspirace pro formální vymezení udržitelnosti MENDELU vychází ze 17 cílů udržitelného rozvoje (SDGs), které představují program rozvoje do roku 2030. Široké zaměření MENDELU ve vzdělávání a ve vědě a výzkumu tvoří dobrý základ pro integraci principů jednotlivých cílů OSN do vnitřního prostředí univerzity. Zapojení do hodnocení ve zvolených mezinárodních žebříčcích vysokých škol a podpora dalšího žebříčku v oblasti SDG je jedním z navrhovaných opatření plánu realizace Strategického záměru.